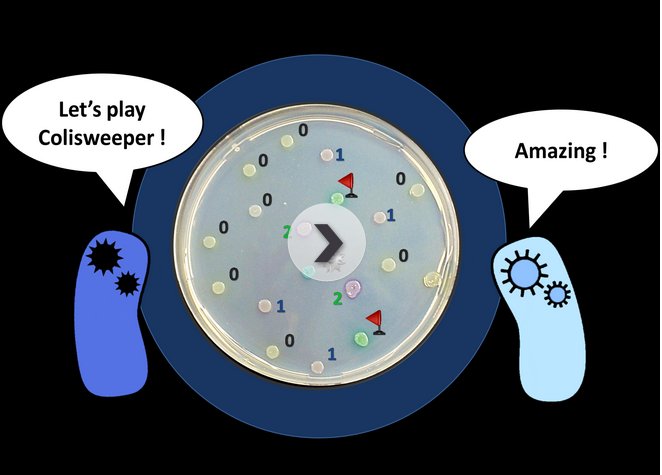

We’re thinking of our visit to this year’s International Genetically Engineered Machines competition as our gold ticket to Willy Wonka’s chocolate factory. You know, “Come with me, and you’ll be in a world of pure imagination.” Or something.
Synthetic biology’s equivalent to the student robotics championship, iGEM has historically played impresario to the burgeoning field. Using its tools and growing catalogue of genes parts, students compete to create the most useful, most intriguing organisms. This weekend, they showed off bacteria that ride worms, next generation cures for tuberculosis and 243 other projects. Here are our top picks from the finals at MIT. Also, check out our post about the first competition in 2004.